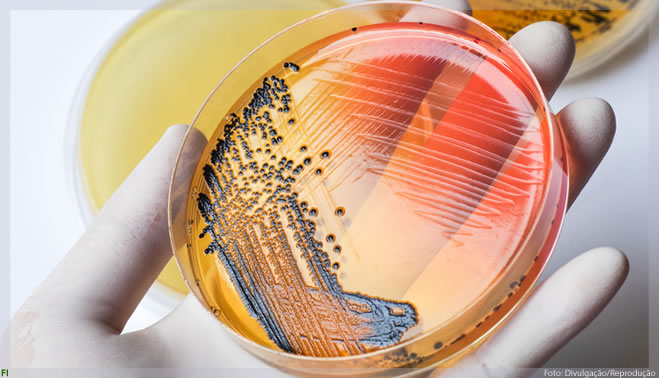

Raquel Rainier criou sensores que detectam Salmonella em alimentos

A #MulherCientista desta semana desenvolveu um dispositivo que identifica Salmonella em 20 minutos – o método tradicional pode levar até 48 horas Segundo a estimativa mais recente da OMS, 10% da população da Terra adoece todos os anos após comer alimentos contaminados. É claro que a indústria testa os alimentos em laboratório à procura de […]
Read more